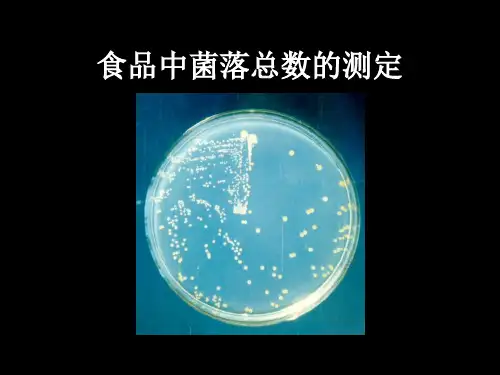

最新.
9
三 、 材料
1、 食品检样 2、 培养基 平板计数培养基,无菌生理盐水或磷酸 盐缓冲液 3、 其它 无菌培养皿,无菌吸管,电炉、恒温培 养箱等。
最新.
10
四、 流程
1、检样
2、做几个适当倍数的稀释液
3、选择2~3个适宜稀释度各1 mL,分别加入 灭菌平皿内
4、平皿内倾注15~20 mL琼脂培养基,混匀
一定条件包括培养基成分、培养温度 和时间、pH、是否需要氧气等。
最新.
4
按国家标准方法规定,即在需氧情况 下, 36 ±1℃培养48±2 h,能在平板 计数琼脂上生长发育的细菌菌落总数。 所以厌氧或微需氧菌、有特殊营养要求 的以及非嗜中温的细菌,由于现有条件 不能满足其生理需求,故难以繁殖生长。
最新.
为菌落总数测定标准。每一个稀释度应 采用两个平皿,大于300的可记为多不 可计。
最新.
20
2、其中一个平板有较大片状菌落生 长时,则不宜采用,而应以无片状菌落 生长的平板作为该稀释度的菌落数;若 片状菌落不到平板的一半,而其余一半 中菌落分布又很均匀,则可以计算半个 平板后乘以2,以代表一个平板的菌落数。
最新.
23
试样 例次
稀释度
10-210Leabharlann 3138052
平
2 均 526
205
菌
3 落 271
60
数
4
284
152
菌量
10-4 选定计数稀释度 /(个/g 或mL)
18
10-3
5.2x104
32 10-3,10-4 (1.56) 2.6x105
12
10-2
(2.2) 2.7x104